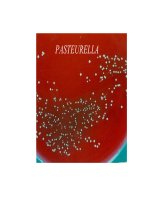
Pasteurella và VIRUS  NEWCASTLE (VI SINH THÚ y SLIDE)

Slide nmvlt c5 new
Bạn đang xem bản rút gọn của tài liệu. Xem và tải ngay bản đầy đủ của tài liệu tại đây (569.93 KB, 83 trang )
Chương 5
Vòng lặp
while / do-while / for
Presenter:
Nhập môn về lập trình (C5)
Slide 1
Learning outcomes
L.O.3.1 – Liệt kê được các kiểu điều khiển và vẽ sơ đồ mô
tả chúng.
L.O.3.2 – Mô tả được được nguyên tắc kết hợp các kiểu
điều khiển để mô tả các giải thuật.
L.O.3.3 – Hiện thực được các kiểu điều khiển bằng ngôn
ngữ C.
L.O.3.4 – Sử dụng các cấu trúc điều khiển để giải quyết bài
tốn thực tế.
Nhập mơn về lập trình (C5)
Slide 2
Vịng lặp là gì ?
In ra 5 dịng chữ “Hello”
printf("Hello\n");
printf("Hello\n");
printf("Hello\n");
printf("Hello\n");
printf("Hello\n");
In ra 100 dịng chữ “Hello”
Nhập mơn về lập trình (C5)
Slide 3
Vịng lặp là gì ?
Bài tốn: Nhập và tính tổng điểm của 10 sinh viên
float a;
float sum = 0;
scanf(“%f”, a);
sum = sum + a;
scanf(“%f”, a);
sum = sum + a;
…………………………………
Nhập mơn về lập trình (C5)
Slide 4
Vịng lặp là gì ?
Chương trình sẽ rất dài nếu yêu cầu nhập và tính tổng
điểm cho 100, 200, 1000 sinh viên v.v.
Để ý thấy chương trình trên lặp đi lặp lại động tác sau
nhiều lần:
scanf(“%f”, a);
sum = sum + a;
Nhập mơn về lập trình (C5)
Slide 5
Vịng lặp là gì ?
Vịng lặp là các phát biểu điều khiển dùng để thực hiện
một công việc nhiều lần.
Các phát biểu thực hiện cơng việc trong vịng lặp gọi là
thân vịng lặp.
Một vịng lặp thường có các phần :
• Khởi động vịng lặp.
• Thân vịng lặp.
• Điều khiển vịng lặp.
Có thể phân loại vịng lặp theo các tiêu chuẩn sau :
• Điều kiện : đi trước hoặc đi sau.
• Số lần lặp : biết trước hoặc khơng biết trước.
Nhập mơn về lập trình (C5)
Slide 6
Vòng lặp
Phân loại
VC++ cho phép sử dụng 3 loại vịng lặp với cú pháp như
sau:
• Vịng lặp while
while (condition) statement;
• Vịng lặp do
do statement while (condition);
• Vịng lặp for
for (initopt ; condopt ; loopopt ) statement;
Nhập môn về lập trình (C5)
Slide 7
Vòng lặp while
Cú pháp :
while (condition) statement
Nghĩa là : trong khi điều kiện condition cịn đúng thì làm
phát biểu statement.
• condition là biểu thức luận lý điều khiển vòng lặp:
Đúng thì lặp.
Sai thì kết thúc.
• statement có thể là phát biểu ghép { ... }.
Vòng lặp while là vịng lặp có điều kiện đi trước và số lần
lặp khơng biết trước.
Nhập mơn về lập trình (C5)
Slide 8
Vịng lặp while
Lưu đờ vận hành
Điều kiện đi trước
condition
Sai
Đúng
Statement
Kết thúc lặp
Nhập mơn về lập trình (C5)
Slide 9
Vòng lặp while
In ra các số từ 1 đến 10
int count;
count = 1; // initialize count
printf(“%d ", count);
count = count + 1;
printf(“%d ", count);
count = count + 1;
printf(“%d ", count);
count = count + 1;
…………………………………………………………..
Nhập mơn về lập trình (C5)
Slide 10
Vịng lặp while
Nhập mơn về lập trình (C5)
Slide 11
Vòng lặp while
int count;
count = 1; // initialize count
while (count <= 10)
{
printf("%d ", count);
count = count + 1;
}
Nhập môn về lập trình (C5)
// increment count
Slide 12
Lặp dựa trên biến đếm
Bài tốn:
• Cần nhập 10 giá trị số thực, sau đó tính giá trị trung bình của 10
giá trị trên
gán total (tổng điểm) bằng 0
gán biến đếm số lần nhập điểm bằng 1
while biến đếm nhỏ hơn hoặc bằng 10
yêu cầu người dùng nhập giá trị tiếp theo
đọc giá trị
cộng giá trị này vào total
cộng biến đếm lên 1
giá trị trung bình bằng total chia cho 10
in giá trị trung bình
Nhập mơn về lập trình (C5)
Slide 13
Lặp dựa trên biến đếm
Kỹ thuật sử dụng một biến để đếm số lần lặp
Vòng lặp dừng khi biến đếm vượt quá một số cho trước
Gọi là lặp dựa trên biến đếm (counter-controlled
repitition)
Lặp hữu hạn vì biết trước số lần lặp
Hãy hiện thực đoạn mã giả trên vào chương trình mẫu
Nhập mơn về lập trình (C5)
Slide 14
Lặp dựa trên biến đếm
int
float
counter;
val, total, average;
total = 0.0;
counter = 1;
while (counter <= 10){
printf("Nhap gia tri: ");
scanf("%f", &val);
total = total + val;
counter = counter + 1;
}
average = total/10.0;
printf("Gia tri trung binh la %f", average);
Nhập mơn về lập trình (C5)
Slide 15
Lặp dựa trên biến đếm
Nhập mơn về lập trình (C5)
Slide 16
Lặp dựa trên biến cờ
Bài tốn:
• Viết ứng dụng tính điểm trung bình cho lớp, với số sinh viên ngẫu
nhiên trong mỗi lần nhập điểm
Khác với bài toán trước:
• Chúng ta khơng biết trước số lần nhập
• Làm sao biết khi nào dừng nhập điểm?
Nhập môn về lập trình (C5)
Slide 17
Lặp dựa trên biến cờ
Dùng biến cờ (sentinel) để báo kết thúc nhập
Giá trị biến cờ phải không lẫn lộn với giá trị nhập vào có
nghĩa
•
•
•
•
Điểm là số nguyên không âm
Chọn giá trị biến cờ là -1
95, 96, 75, 89 rồi -1
Trung bình điểm sẽ là (95 + 96 + 75 + 89)/4
Xây dựng giải thuật để giải bài tốn
Nhập mơn về lập trình (C5)
Slide 18
Từ trên xuống, tinh chỉnh từng
bước
Kỹ thuật xây dựng ứng dụng có cấu trúc chặt chẽ
Trên là một câu lệnh thể hiện chức năng chung của ứng
dụng
xác định điểm trung bình của lớp
Chỉ thể hiện ứng dụng, chưa đủ để viết ứng dụng C#
Bắt đầu tinh chỉnh
Nhập môn về lập trình (C5)
Slide 19
Từ trên xuống, tinh chỉnh từng
bước
Chia trên thành các tác vụ nhỏ hơn và liệt kê theo thứ tự
thực hiện
Bước tinh chỉnh đầu tiên:
nhập
khởi tạo biến
nhập giá trị, tính tổng lại rồi đếm số điểm đã
tính tốn và in ra điểm trung bình
Mỗi lần tinh chỉnh mơ tả cùng giải thuật, chỉ khác về mức
độ chi tiết
Ba bước chung: khởi tạo, nhập và xử lý biến, tính tốn
và xuất kết quả
Nhập mơn về lập trình (C5)
Slide 20